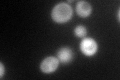
YKL067W

View description
Nucleoside diphosphate kinase, catalyzes the transfer of gamma phosphates from nucleoside triphosphates, usually ATP, to nucleoside diphosphates by a mechanism that involves formation of an autophosphorylated enzyme intermediate
Localization:
Intensity:
Fold change:
Significance:
-
C’ GFP library in SD

cytosol145.66 -
N' NOP1pr-GFP in SD

cytosol,nucleus65.0857 -
N' TEF2pr-mCherry in SD

missing0 -
N' NATIVEpr-GFP in SD

below threshold20.5465 -
N' TEF2pr-VC and Cyto-VN in SD

below threshold23.7836 -
C’ GFP library in SD+DTT

cytosol227.411.56Yes -
C’ GFP library in SD+H2O2
cytosol122.690.84No -
C’ GFP library in Starvation Media

nucleusN/AN/AYes -
C’ GFP library on the background of Pup2-DaMP

cytosol -
C’ GFP library on the background of CCT mutant

cytosol128.5720.882582No
